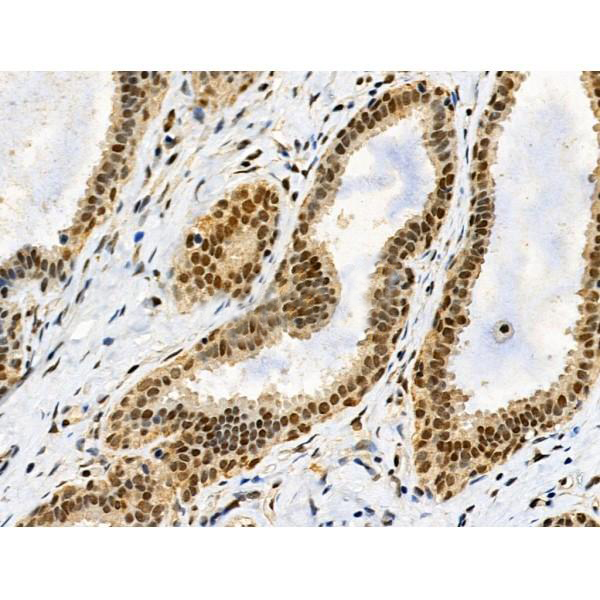
product-image-AAA329327_IHC8.jpg

Specificity
Phospho-HSF1 (Ser326) Antibody detects endogenous levels of HSF1 only when phosphorylated at Ser326.
Purity/Purification
The antibody is from purified rabbit serum by affinity purification via sequential chromatography on phospho-peptide and non-phospho-peptide affinity columns.
Form/Format
Liquid. Rabbit IgG in phosphate buffered saline, pH7.4, 150mM NaCl, 0.02% sodium azide and 50% glycerol.
Concentration
1mg/ml (varies by lot)
Applicable Applications for anti-HSF1 antibody
ELISA (Peptide ELISA), IHC (Immunohistochemistry)
Immunogen
A synthesized peptide derived from human HSF1 around the phosphorylation site of Ser326.
Post Translational Modifications
Phosphorylated. Phosphorylated in unstressed cells; this phosphorylation is constitutive and implicated in the repression of HSF1 transcriptional activity. Phosphorylated on Ser-121 by MAPKAPK2; this phosphorylation promotes interaction with HSP90 proteins and inhibits HSF1 homotrimerization, DNA-binding and transactivation activities. Phosphorylation on Ser-303 by GSK3B/GSK3-beta and on Ser-307 by MAPK3 within the regulatory domain is involved in the repression of HSF1 transcriptional activity and occurs in a RAF1-dependent manner. Phosphorylation on Ser-303 and Ser-307 increases HSF1 nuclear export in a YWHAE- and XPO1/CRM1-dependent manner. Phosphorylation on Ser-307 is a prerequisite for phosphorylation on Ser-303. According to Ser-303 is not phosphorylated in unstressed cells. Phosphorylated on Ser-419 by PLK1; phosphorylation promotes nuclear translocation upon heat shock. Hyperphosphorylated upon heat shock and during the attenuation and recovery phase period of the heat shock response. Phosphorylated on Thr-142; this phosphorylation increases HSF1 transactivation activity upon heat shock. Phosphorylation on Ser-230 by CAMK2A; this phosphorylation enhances HSF1 transactivation activity upon heat shock. Phosphorylation on Ser-326 by MAPK12; this phosphorylation enhances HSF1 nuclear translocation, homotrimerization and transactivation activities upon heat shock. Phosphorylated on Ser-320 by PRKACA/PKA; this phosphorylation promotes nuclear localization and transcriptional activity upon heat shock. Phosphorylated on Ser-363 by MAPK8; this phosphorylation occurs upon heat shock, induces HSF1 translocation into nuclear stress bodies and negatively regulates transactivation activity. Neither basal nor stress-inducible phosphorylation on Ser-230, Ser-292, Ser-303, Ser-307, Ser-314, Ser-319, Ser-320, Thr-323, Ser-326, Ser-338, Ser-344, Ser-363, Thr-367, Ser-368 and Thr-369 within the regulatory domain is involved in the regulation of HSF1 subcellular localization or DNA-binding activity; however, it negatively regulates HSF1 transactivation activity. Phosphorylated on Ser-216 by PLK1 in the early mitotic period; this phosphorylation regulates HSF1 localization to the spindle pole, the recruitment of the SCF (BTRC) ubiquitin ligase complex inducing HSF1 degradation, and hence mitotic progression. Dephosphorylated on Ser-121, Ser-307, Ser-314, Thr-323 and Thr-367 by phosphatase PPP2CA in an IER5-dependent manner, leading to HSF1-mediated transactivation activity. Sumoylated with SUMO1 and SUMO2 upon heat shock in a ERK2-dependent manner. Sumoylated by SUMO1 on Lys-298; sumoylation occurs upon heat shock and promotes its localization to nuclear stress bodies and DNA-binding activity. Phosphorylation on Ser-303 and Ser-307 is probably a prerequisite for sumoylation. Acetylated on Lys-118; this acetylation is decreased in a IER5-dependent manner. Acetylated on Lys-118, Lys-208 and Lys-298; these acetylations occur in a EP300-dependent manner. Acetylated on Lys-80; this acetylation inhibits DNA-binding activity upon heat shock. Deacetylated on Lys-80 by SIRT1; this deacetylation increases DNA-binding activity.Ubiquitinated by SCF (BTRC) and degraded following stimulus-dependent phosphorylation at Ser-216 by PLK1 in mitosis. Polyubiquitinated. Undergoes proteasomal degradation upon heat shock and during the attenuation and recovery phase period of the heat shock response.
Subunit Structure
Monomer; cytoplasmic latent and transcriptionally inactive monomeric form in unstressed cells. Homotrimer; in response to stress, such as heat shock, homotrimerizes and translocates into the nucleus, binds to heat shock element (HSE) sequences in promoter of heat shock protein (HSP) genes and acquires transcriptional ability. Interacts (via monomeric form) with FKBP4; this interaction occurs in unstressed cells. Associates (via monomeric form) with HSP90 proteins in a multichaperone complex in unnstressed cell; this association maintains HSF1 in a non-DNA-binding and transcriptional inactive form by preventing HSF1 homotrimerization. Homotrimeric transactivation activity is modulated by protein-protein interactions and post-translational modifications. Interacts with HSP90AA1; this interaction is decreased in a IER5-dependent manner, promoting HSF1 accumulation in the nucleus, homotrimerization and DNA-binding activities. Part (via regulatory domain in the homotrimeric form) of a large heat shock-induced HSP90-dependent multichaperone complex at least composed of FKBP4, FKBP5, HSP90 proteins, PPID, PPP5C and PTGES3; this association maintains the HSF1 homotrimeric DNA-bound form in a transcriptionally inactive form. Interacts with BAG3 (via BAG domain); this interaction occurs in normal and heat-shocked cells promoting nuclear shuttling of HSF1 in a BAG3-dependent manner. Interacts (via homotrimeric and hyperphosphorylated form) with FKBP4; this interaction occurs upon heat shock in a HSP90-dependent multichaperone complex. Interacts (via homotrimeric form preferentially) with EEF1A proteins. In heat shocked cells, stress-denatured proteins compete with HSF1 homotrimeric DNA-bound form for association of the HSP90-dependent multichaperone complex, and hence alleviating repression of HSF1-mediated transcriptional activity. Interacts (via homotrimeric form preferentially) with DAXX; this interaction relieves homotrimeric HSF1 from repression of its transcriptional activity by HSP90-dependent multichaperone complex upon heat shock. Interacts (via D domain and preferentially with hyperphosphorylated form) with JNK1; this interaction occurs under both normal growth conditions and immediately upon heat shock. Interacts (via D domain and preferentially with hyperphosphorylated form) with MAPK3; this interaction occurs upon heat shock. Interacts with IER5 (via central region); this interaction promotes PPP2CA-induced dephosphorylation on Ser-121, Ser-307, Ser-314, Thr-323 and Thr-367 and HSF1 transactivation activity. Found in a ribonucleoprotein complex composed of the HSF1 homotrimeric form, translation elongation factor eEF1A proteins and non-coding RNA heat shock RNA-1 (HSR1); this complex occurs upon heat shock and stimulates HSF1 DNA-binding activity. Interacts (via transactivation domain) with HSPA1A/HSP70 and DNAJB1; these interactions result in the inhibition of heat shock- and HSF1-induced transcriptional activity during the attenuation and recovery phase from heat shock. Interacts (via Ser-303 and Ser-307 phosphorylated form) with YWHAE; this interaction promotes HSF1 sequestration in the cytoplasm in an ERK-dependent manner. Found in a complex with IER5 and PPP2CA. Interacts with TPR; this interaction increases upon heat shock and stimulates export of HSP70 mRNA. Interacts with SYMPK (via N-terminus) and CSTF2; these interactions occur upon heat shock. Interacts (via transactivation domain) with HSPA8. Interacts with EEF1D; this interaction occurs at heat shock promoter element (HSE) sequences. Interacts with MAPKAPK2. Interacts with PRKACA/PKA. Interacts (via transactivation domain) with GTF2A2. Interacts (via transactivation domain) with GTF2B. Interacts (via transactivation domain) with TBP. Interacts with CDK9, CCNT1 and EP300. Interacts (via N-terminus) with XRCC5 (via N-terminus) and XRCC6 (via N-terminus); these interactions are direct and prevent XRCC5/XRCC6 heterodimeric binding and non-homologous end joining (NHEJ) repair activities induced by ionizing radiation (IR). Interacts with PLK1; this interaction occurs during the early mitotic period, increases upon heat shock but does not modulate neither HSF1 homotrimerization and DNA-binding activities. Interacts (via Ser-216 phosphorylated form) with CDC20; this interaction occurs in mitosis in a MAD2L1-dependent manner and prevents PLK1-stimulated degradation of HSF1 by blocking the recruitment of the SCF (BTRC) ubiquitin ligase complex. Interacts with MAD2L1; this interaction occurs in mitosis. Interacts with BTRC; this interaction occurs during mitosis, induces its ubiquitin-dependent degradation following stimulus-dependent phosphorylation at Ser-216, a process inhibited by CDC20. Interacts with HSP90AA1 and HSP90AB1.
Similarity
In unstressed cells, spontaneous homotrimerization is inhibited (PubMed:7935471, PubMed:7760831). Intramolecular interactions between the hydrophobic repeat HR-A/B and HR-C regions are necessary to maintain HSF1 in the inactive, monomeric conformation (PubMed:7935471, PubMed:7623826). Furthermore, intramolecular interactions between the regulatory domain and the nonadjacent transactivation domain prevents transcriptional activation, a process that is relieved upon heat shock (PubMed:7760831). The regulatory domain is necessary for full repression of the transcriptional activation domain in unstressed cells through its phosphorylation on Ser-303 and Ser-307 (PubMed:8946918, PubMed:9121459). In heat stressed cells, HSF1 homotrimerization occurs through formation of a three-stranded coiled-coil structure generated by intermolecular interactions between HR-A/B regions allowing DNA-binding activity (PubMed:7935471). The D domain is necessary for translocation to the nucleus, interaction with JNK1 and MAPK3 and efficient JNK1- and MAPK3-dependent phosphorylation (PubMed:10747973). The regulatory domain confers heat shock inducibility on the transcriptional transactivation domain (PubMed:7760831). The regulatory domain is necessary for transcriptional activation through its phosphorylation on Ser-230 upon heat shock (PubMed:11447121). 9aaTAD is a transactivation motif present in a large number of yeast and animal transcription factors (PubMed:17467953).Belongs to the HSF family.
Subcellular Location
Nucleus. Cytoplasm. Nucleus>Nucleoplasm. Cytoplasm>Perinuclear region. Cytoplasm>Cytoskeleton>Spindle pole. Cytoplasm>Cytoskeleton>Microtubule organizing center>Centrosome. Chromosome>Centromere>Kinetochore.
Note: The monomeric form is cytoplasmic in unstressed cells (PubMed:8455624, PubMed:26159920). Predominantly nuclear protein in both unstressed and heat shocked cells (PubMed:10413683, PubMed:10359787). Translocates in the nucleus upon heat shock (PubMed:8455624). Nucleocytoplasmic shuttling protein (PubMed:26159920). Colocalizes with IER5 in the nucleus (PubMed:27354066). Colocalizes with BAG3 to the nucleus upon heat stress (PubMed:8455624, PubMed:26159920). Localizes in subnuclear granules called nuclear stress bodies (nSBs) upon heat shock (PubMed:11447121, PubMed:11514557, PubMed:10359787, PubMed:25963659, PubMed:10747973, PubMed:24581496, PubMed:19229036). Colocalizes with SYMPK and SUMO1 in nSBs upon heat shock (PubMed:11447121, PubMed:12665592, PubMed:11514557, PubMed:14707147, PubMed:10359787). Colocalizes with PRKACA/PKA in the nucleus and nSBs upon heat shock (PubMed:21085490). Relocalizes from the nucleus to the cytoplasm during the attenuation and recovery phase period of the heat shock response (PubMed:26159920). Translocates in the cytoplasm in a YWHAE- and XPO1/CRM1-dependent manner (PubMed:12917326). Together with histone H2AX, redistributed in discrete nuclear DNA damage-induced foci after ionizing radiation (IR) (PubMed:26359349). Colocalizes with calcium-responsive transactivator SS18L1 at kinetochore region on the mitotic chromosomes (PubMed:18794143). Colocalizes with gamma tubulin at centrosome (PubMed:18794143). Localizes at spindle pole in metaphase (PubMed:18794143). Colocalizes with PLK1 at spindle poles during prometaphase (PubMed:18794143).
Preparation and Storage
Store at -20 degree C. Stable for 12 months from date of receipt.